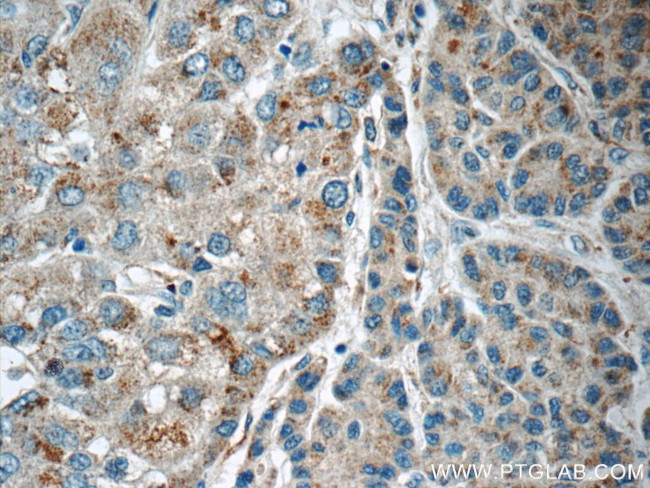
LMF1 Antibody in Immunohistochemistry (Paraffin) (IHC (P))

Search
Proteintech
LMF1 Polyclonal Antibody
{{$productOrderCtrl.translations['antibody.pdp.commerceCard.promotion.promotions']}}
{{$productOrderCtrl.translations['antibody.pdp.commerceCard.promotion.viewpromo']}}
{{$productOrderCtrl.translations['antibody.pdp.commerceCard.promotion.promocode']}}: {{promo.promoCode}} {{promo.promoTitle}} {{promo.promoDescription}}. {{$productOrderCtrl.translations['antibody.pdp.commerceCard.promotion.learnmore']}}
产品信息
16812-1-AP
种属反应
宿主/亚型
分类
类型
抗原
偶联物
形式
浓度
规格
纯化类型
保存液
内含物
保存条件
运输条件
产品详细信息
Immunogen sequence: VRRAANVSL GVLLAWLSVP VVLNLLSSRQ VMNTHFNSLH IVNTYGAFGS ITKERAEVIL QGTASSNASA PDAMWEDYEF KCKPGDPSRR PCLISPYHYR LDWLMWFAAF QTYEHNDWII HLAGKLLASD AEALSLLAHN PFAGRPPPRW VRGEHYRYKF SRPGGRHAAE GKWWVRKRIG AYFPPLSLEE LRPYFRDRGW PL (286-486 aa encoded by BC010738)
靶标信息
Involved in the maturation of specific proteins in the endoplasmic reticulum. Required for maturation and transport of active lipoprotein lipase (LPL) through the secretory pathway. Each LMF1 molecule chaperones 50 or more molecules of LPL. [UniProt]
仅用于科研。不用于诊断过程。未经明确授权不得转售。
生物信息学
蛋白别名: FLJ12681; FLJ22302; Lipase maturation factor 1; Transmembrane protein 112; unnamed protein product
基因别名: 2400010G15Rik; AW822050; C16orf26; cld; HMFN1876; JFP11; LMF1; RGD1310180; TMEM112; TMEM112A
UniProt ID: (Human) Q96S06, (Mouse) Q3U3R4
Entrez Gene ID: (Human) 64788, (Mouse) 76483, (Rat) 360495